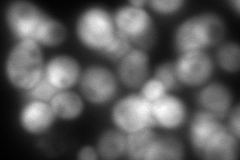

View description
Anthranilate phosphoribosyl transferase of the tryptophan biosynthetic pathway, catalyzes the phosphoribosylation of anthranilate, subject to the general control system of amino acid biosynthesis
Localization:
Intensity:
Fold change:
Significance:
-
C’ GFP library in SD

cytosol45.78 -
N' NOP1pr-GFP in SD

cytosol131.365 -
N' TEF2pr-mCherry in SD
cytosol205.472 -
N' NATIVEpr-GFP in SD

cytosol54.8357 -
N' TEF2pr-VC and Cyto-VN in SD

cytosol74.7832 -
C’ GFP library in SD+DTT

cytosol26.240.57Yes -
C’ GFP library in SD+H2O2

cytosol51.211.11No -
C’ GFP library in Starvation Media

cytosol72.911.59Yes -
C’ GFP library on the background of Pup2-DaMP

cytosol -
C’ GFP library on the background of CCT mutant

cytosolN/AN/ANo
